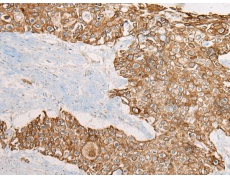
一抗

中文名稱:兔抗CAGE1多克隆抗體
英文名稱: Anti-CAGE1 rabbit polyclonal antibody
別 名: cancer antigen 1; CT3; CT95; CTAG3; bA69L16.7
抗 原: CAGE1
相關(guān)類別: 一抗
儲 存: 冷凍(-20℃)
宿 主: Rabbit
標 記 物: Unconjugate
克隆類型: rabbit polyclonal
技術(shù)規(guī)格
|
Background: |
Cancer-associated gene 1 protein (CAGE1) is initially identified as a cancer/testis antigen. CAGE1 is mainly a nuclear protein that displays high expression in testis among normal tissues, and wide expression in various cancer tissues and cancer cell lines. CAGE1 may be associated with tumor progression, while the exact function of CAGE-1 is not well understood. |
|
Applications: |
ELISA, WB, IHC |
|
Name of antibody: |
CAGE1 |
|
Immunogen: |
Fusion protein of human CAGE1 |
|
Full name: |
cancer antigen 1 |
|
Synonyms: |
CT3; CT95; CTAG3; bA69L16.7 |
|
SwissProt: |
Q8TC20 |
|
ELISA Recommended dilution: |
5000-10000 |
|
IHC positive control: |
Human prostate cancer; |
|
IHC Recommend dilution: |
25-100 |
|
WB Predicted band size: |
90 kDa |
|
WB Positive control: |
Jurkat cell lysate |
|
WB Recommended dilution: |
200-1000 |


 購物車
購物車 幫助
幫助
 021-54845833/15800441009
021-54845833/15800441009